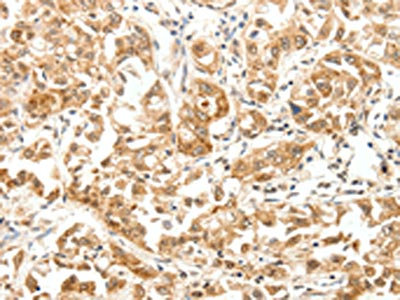

PAK7 Antibody
-
中文名稱:PAK7兔多克隆抗體
-
貨號(hào):CSB-PA158224
-
規(guī)格:¥1100
-
圖片:
-
The image on the left is immunohistochemistry of paraffin-embedded Human ovarian cancer tissue using CSB-PA158224(PAK7 Antibody) at dilution 1/10, on the right is treated with fusion protein. (Original magnification: ×200)
-
The image on the left is immunohistochemistry of paraffin-embedded Human lung cancer tissue using CSB-PA158224(PAK7 Antibody) at dilution 1/10, on the right is treated with fusion protein. (Original magnification: ×200)
-
Gel: 10%SDS-PAGE, Lysate: 40 μg, Lane: Human fetal kidney tissue, Primary antibody: CSB-PA158224(PAK7 Antibody) at dilution 1/100, Secondary antibody: Goat anti rabbit IgG at 1/8000 dilution, Exposure time: 3 minutes
-
-
其他:
產(chǎn)品詳情
-
Uniprot No.:
-
基因名:
-
別名:EC 2.7.11.1 antibody; KIAA1264 antibody; MGC26232 antibody; p21 activated kinase 7 antibody; p21 protein (Cdc42/Rac)-activated kinase 7 antibody; p21(CDKN1A) activated kinase 7 antibody; p21-activated kinase 5 antibody; p21-activated kinase 7 antibody; PAK 5 antibody; PAK 7 antibody; PAK-5 antibody; PAK-7 antibody; PAK5 antibody; PAK7 antibody; PAK7_HUMAN antibody; Protein kinase PAK5 antibody; Serine/threonine protein kinase PAK 7 antibody; Serine/threonine-protein kinase PAK 7 antibody
-
宿主:Rabbit
-
反應(yīng)種屬:Human,Mouse,Rat
-
免疫原:Fusion protein of Human PAK7
-
免疫原種屬:Homo sapiens (Human)
-
標(biāo)記方式:Non-conjugated
-
抗體亞型:IgG
-
純化方式:Antigen affinity purification
-
濃度:It differs from different batches. Please contact us to confirm it.
-
保存緩沖液:-20°C, pH7.4 PBS, 0.05% NaN3, 40% Glycerol
-
產(chǎn)品提供形式:Liquid
-
應(yīng)用范圍:ELISA,WB,IHC
-
推薦稀釋比:
Application Recommended Dilution ELISA 1:1000-1:5000 WB 1:200-1:1000 IHC 1:15-1:50 -
Protocols:
-
儲(chǔ)存條件:Upon receipt, store at -20°C or -80°C. Avoid repeated freeze.
-
貨期:Basically, we can dispatch the products out in 1-3 working days after receiving your orders. Delivery time maybe differs from different purchasing way or location, please kindly consult your local distributors for specific delivery time.
-
用途:For Research Use Only. Not for use in diagnostic or therapeutic procedures.
相關(guān)產(chǎn)品
靶點(diǎn)詳情
-
功能:Serine/threonine protein kinase that plays a role in a variety of different signaling pathways including cytoskeleton regulation, cell migration, proliferation or cell survival. Activation by various effectors including growth factor receptors or active CDC42 and RAC1 results in a conformational change and a subsequent autophosphorylation on several serine and/or threonine residues. Phosphorylates the proto-oncogene RAF1 and stimulates its kinase activity. Promotes cell survival by phosphorylating the BCL2 antagonist of cell death BAD. Phosphorylates CTNND1, probably to regulate cytoskeletal organization and cell morphology. Keeps microtubules stable through MARK2 inhibition and destabilizes the F-actin network leading to the disappearance of stress fibers and focal adhesions.
-
基因功能參考文獻(xiàn):
- PAK5 Induces EMT and Promotes Cell Migration and Invasion by Activating the PI3K/AKT Pathway in Ovarian Cancer. PMID: 30245957
- Mechanistic studies demonstrated that miR-106a-5p directly bound to the 3'-UTR of the PAK5 mRNA and mediated a decrease in the protein expression of PAK5. PMID: 29072688
- PAK5-mediated phosphorylation and nuclear translocation of NF-kappaB-p65 promotes breast cancer cell proliferation in vitro and in vivo PMID: 29041983
- p21-activated kinase (PAK7) was identified as the putative target of miR492 in osteosarcoma (OS), and we further found a significantly inverse correlation between PAK7 and miR492 in OS specimens. PMID: 28677719
- As PAK7 has been implicated in the progression of various tumor types, silencing the expression of PAK7 via pairing with miR526a may be an effective strategy in tumor suppression. PMID: 28560394
- These findings indicate that aberrant PAK7 expression is associated with the occurrence of metastasis and poor clinical outcomes of human colon cancer by promoting the epithelial to mesechymal transition PMID: 27323857
- Data suggest expression of ECAD (E-cadherin) in bladder cancer cell lines correlates with presence of intercellular junctions and level of PAK5 (p21-activated kinase PAK5 protein) expression; endogenous PAK5 is localized to intercellular junctions and interacts with ECAD; depletion of PAK5 expression reduces integrity of intercellular junctions; PAK5 mRNA levels are reduced in bladder cancer compared with normal controls. PMID: 28232500
- model suggests PAK5 self-association interferes with AID binding to the catalytic domain, thus maintaining its high activity. PMID: 27095851
- PAK7 expression is significantly downregulated in human masticatory mucosa during wound healing PMID: 28005267
- PAK7 is overexpressed in human esophageal squamous cell cancer samples and correlated with lymph node metastasis. PMID: 26682509
- E47 is a novel substrate of PAK5, and PAK5-mediated phosphorylation of E47 promotes epithelial-mesenchymal transition and metastasis of colon cancer. PMID: 26212009
- Aurora-A induced PAK7 expression in esophageal cancer cells. PMID: 25436453
- results suggest that the inhibition of PAK5 by RNA interference might efficiently suppress tumor development of glioma cells with PAK5 high expression. PMID: 25632266
- miR-129 suppresses tumor cell growth and invasion by targeting PAK5 in hepatocellular carcinoma. PMID: 26116538
- PAK7 promotes cell proliferation and tumorigenesis PMID: 25052921
- It inhibits glioma cell migration and invasion potentially through the PAK5-Egr1-MMP2 signaling pathway. PMID: 24062079
- PAK5 functions as an oncogenic kinase in tumor cellular regulation PMID: 24869804
- Results demonstrate that PAK7 is developmentally co-expressed with another known psychosis risk gene (DISC1) suggesting a potential molecular mechanism involving aberrant synapse development and plasticity. PMID: 24474471
- PAK5 is correlated to human epithelial ovarian cancer (EOC) and increased PAK5 expression promotes EOC progression. PMID: 23877225
- The PAK5-Egr1-MMP2 signaling pathway is a critical regulator of cell migration and invasion in lung cancer cells. PMID: 23696025
- identified three kinases with gain-of-function mutations in lung cancer, namely FGFR4, MAP3K9, and PAK5. Mutations in these kinases are activating toward the ERK pathway, and targeted depletion of the mutated kinases inhibits proliferation PMID: 23836671
- PAK7 is a new hallmark of gastric cancer, PAK7 may contribute to gain of tumor growth potential, acting by affecting the expression of cell cycle regulators. PMID: 23106939
- Data show that both Pak5 and constitutively active Pak4, the founding member of the Group B Paks, directly phosphorylate p120 in vitro. PMID: 20564219
- PAK5 suppresses the activity of microtubule affinity-regulating kinase 2 (MARK2) toward its target, tau protein. PMID: 16014608
- Nucleocytoplasmic shuttling of PAK7 regulates its antiapoptotic properties. PMID: 16581795
- Study demonstrated that PAK5 expression increased significantly with malignant progression of CRC (colorectal cancer), and that PAK5 might promote CRC metastasis by regulating CRC cell adhesion and migration. PMID: 19415746
顯示更多
收起更多
-
亞細(xì)胞定位:Mitochondrion. Cytoplasm. Nucleus. Note=Shuttles between the nucleus and the mitochondria, and mitochondrial localization is essential for the role in cell survival.
-
蛋白家族:Protein kinase superfamily, STE Ser/Thr protein kinase family, STE20 subfamily
-
組織特異性:Predominantly expressed in brain.
-
數(shù)據(jù)庫(kù)鏈接:
Most popular with customers
-
-
YWHAB Recombinant Monoclonal Antibody
Applications: ELISA, WB, IHC, IF, FC
Species Reactivity: Human, Mouse, Rat
-
Phospho-YAP1 (S127) Recombinant Monoclonal Antibody
Applications: ELISA, WB, IHC
Species Reactivity: Human
-
-
-
-
-